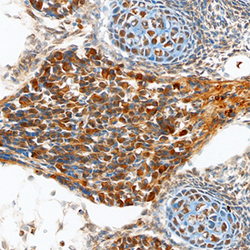

Antibody data
- Antibody Data
- Antigen structure
- References [1]
- Comments [0]
- Validations
- Western blot [1]
- Immunohistochemistry [1]
Submit
Validation data
Reference
Comment
Report error
- Product number
- AF4578 - Provider product page

- Provider
- R&D Systems
- Product name
- Human/Mouse/Rat Teneurin-2 Antibody
- Antibody type
- Polyclonal
- Description
- Immunogen affinity purified. Detects Teneurin-2 in direct ELISAs and Western blots. In direct ELISAs, approximately 15% cross-reactivity with recombinant human (rh) Teneurin-3 is observed, and less than 4% cross-reactivity with rhTeneurin-1 is observed.
- Reactivity
- Human, Mouse, Rat
- Host
- Sheep
- Conjugate
- Unconjugated
- Antigen sequence
AAI72353- Isotype
- IgG
- Vial size
- 100 ug
- Concentration
- LYOPH
- Storage
- Use a manual defrost freezer and avoid repeated freeze-thaw cycles. 12 months from date of receipt, -20 to -70 °C as supplied. 1 month, 2 to 8 °C under sterile conditions after reconstitution. 6 months, -20 to -70 °C under sterile conditions after reconstitution.
Submitted references Proteolytically released Lasso/teneurin-2 induces axonal attraction by interacting with latrophilin-1 on axonal growth cones.
Vysokov NV, Silva JP, Lelianova VG, Suckling J, Cassidy J, Blackburn JK, Yankova N, Djamgoz MB, Kozlov SV, Tonevitsky AG, Ushkaryov YA
eLife 2018 Nov 20;7
eLife 2018 Nov 20;7
No comments: Submit comment
Supportive validation
- Submitted by
- R&D Systems (provider)
- Main image

- Experimental details
- Detection of Mouse and Rat Teneurin-2 by Western blot. Western blot shows lysates of mouse brain tissue and rat embryonic cortical neuron cells. PVDF Membrane was probed with 1 µg/mL of Human Teneurin-2 Antigen Affinity-purified Polyclonal Antibody (Catalog # AF4578) followed by HRP-conjugated Anti-Sheep IgG Secondary Antibody (Catalog # HAF016). A specific band was detected for Teneurin-2 at approximately 300 kDa (as indicated). This experiment was conducted under reducing conditions and using Immunoblot Buffer Group 8.
Supportive validation
- Submitted by
- R&D Systems (provider)
- Main image
- Experimental details
- Teneurin-2 in Mouse Brain. Teneurin-2 was detected in immersion fixed frozen sections of embryonic mouse brain using Sheep Anti-Human/Mouse/Rat Teneurin-2 Antigen Affinity-purified Polyclonal Antibody (Catalog # AF4578) at 10 µg/mL overnight at 4 °C. Tissue was stained using the Anti-Sheep HRP-DAB Cell & Tissue Staining Kit (brown; Catalog # CTS019) and counterstained with hematoxylin (blue). Specific staining was localized to neurons in dorsal root ganglia and cells in cartilage primordium. View our protocol for Chromogenic IHC Staining of Frozen Tissue Sections.
 Explore
Explore Validate
Validate Learn
Learn Western blot
Western blot